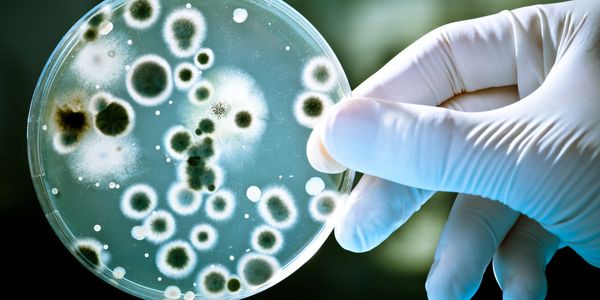

Anti-Gravity Holistic Health Therapy and Life Counseling

PROCESS 1: CHECK - tune - reCHECK
State-of-the-art, non-invasive bioresonance AI and quantum energy-based 3D screening machines from the US, UK, Germany, and Russia enable us to map the health status of the brain and body with precision. These advanced technologies go beyond detecting physical symptoms—they trace and address underlying abnormal processes, aiming for lasting, root-cause restoration of health. The scanners' graphical imaging capabilities provide clear visualizations for understanding health conditions, comparing before-and-after states, formulating personalized holistic therapeutic plans, and tracking progress and efficacy over time.

process 2: INGEST, DIGEST, ABSORB
Health is influenced not only by what we eat and drink but also by what we avoid. Real-life experience often goes beyond textbook models. Urban eating habits burden the body with nutrient-poor, chemical-laden foods filled with additives, preservatives, and pesticides. Modifying dietary choices and selecting the right water with a balanced mix of electrolytes can lead to rapid and significant health improvements. Optimizing digestion and absorption is crucial to ensuring that essential nutrients are efficiently transported to the body's cellular "factories" for energy production. We provide science-backed guidance on nutrition and supplementation, helping to choose the right foods, water, and additional nutrients to bridge any deficiencies. In particular, enzymatic and probiotic therapies play a key role in maintaining a clean digestive tract, enhancing digestion, and supporting smooth intestinal function for effective nutrient absorption and waste elimination.
PROCESS 3: CONGESTANTS, GERMS AND TOXIN EVICT
Toxins from both external environmental sources and internal metabolic processes can become dangerous if not promptly eliminated. When these toxins accumulate, they can harden and create blockages in the body's vital systems—clogging filters like the lungs and kidneys, burdening pumps like the heart, and obstructing pathways such as blood vessels, lymphatic channels, and intestines. Over time, this toxic buildup can slowly poison the body, causing damage, dysfunction, and degeneration. Additionally, these blockages create ideal environments for parasites and harmful microbes that feed on body tissues. When essential nutrients, oxygen, water, hormones, enzymes, neurotransmitters, and immune cells cannot reach their destinations, and toxic waste cannot be properly drained, health deteriorates. This leads to issues such as kidney stones, gallstones, cholesterol buildup, and uric acid crystallization, as well as disruptions like abnormal cell growth and impaired bowel function, often resulting in constipation.
Comprehensive detoxification is essential to clearing clogged toxins, breaking down parasitic biofilm, softening plaque, neutralizing acidity, and removing waste, cell debris, and allergens. Undertaking full-body detoxification methods helps restore balance and strengthen the body's natural healing capacity.

process 4: pump, Tubes, valves and DEFY-gravity
Nothing functions properly if essential raw materials fail to reach where they are needed. For example, when oxygen and nutrients cannot reach the brain due to poor circulation, it can lead to vascular dementia. The body depends on a continuous supply of hormones, enzymes, immune cells, water, nutrients, and oxygen to sustain its functions and maintain health. The body’s circulatory system operates through an intricate network of pumps, filters, and directional valves that transport raw materials via blood and lymphatic fluid while simultaneously removing toxins. The heart serves as the primary pump, but circulation is also hugely affected by Gravity. As a result, ensuring an upward flow of blood and lymph—especially to the brain—becomes increasingly challenging with age. Weakening vascular and intestinal walls, often caused by poor nutrition and lack of exercise, further exacerbate these issues. To counteract these challenges, we have developed a comprehensive approach that includes targeted nutrition, physical movement, manual and automated lymphatic drainage, and fast-acting decongestive therapies. Our proprietary Painknots Instant Pain Release Method and specialized Anti-Gravity Machines provide vital support to keep circulation flowing efficiently, ensuring optimal delivery of nutrients and oxygen while preventing congestion and stagnation.

PROCESS 5: think, REST, destress, prevent BURNOUT
Overthinking and overworking the brain drain energy from the rest of the body, impairing its ability to function and repair itself. This imbalance can lead to physical restrictions and energy blockages, contributing to chronic pain, anxiety, and depressive responses.
Daily life presents countless stressors—physical, emotional, and mental traumas, existential crises, financial instability, fear, anxiety, depression, insomnia, and even neurodegenerative conditions like dementia. Identifying and addressing these triggers can free the mind, restore energy, and promote motivation, productivity, spiritual growth, and joy. To support mental resilience, it is essential to assess rest, sleep quality, and the body's ability to repair itself. Lifestyle habits should be adjusted to incorporate effective calming techniques such as Mindfulness Meditation, Stoicism, and Cognitive-Behavioral Therapy (CBT). Additionally, Grief and Thanatology End-of-Life Counseling can provide crucial support in navigating loss and existential challenges, helping to prevent excessive stress, burnout, and mental disorders.

PROCESS 6: ACIDITY, IMMUNITY, INFLAMMATION
Our internal balance—pH levels (acidity-alkalinity), electrolyte composition, oxygen levels, and hydration—creates the optimal environment for beneficial bacteria to thrive, enzymes to cleanse, cells to regulate permeability, and blood and lymph to circulate efficiently. This delicate biochemical harmony is essential for proper cellular respiration, nutrient absorption, and detoxification.
However, when toxins accumulate and cellular or organ function deteriorates, this balance is disrupted, leading to impaired critical chemical reactions. Over time, these imbalances can weaken the immune system, causing chronic inflammation, tissue dysfunction, abnormal cell growth, and ultimately, cell death. Maintaining equilibrium within the body is essential for sustaining health.
Our Back-2-Balance Protocol is specifically designed to restore and maintain this delicate internal balance, ensuring optimal function and long-term well-being.

PROCESS 7: STRUCTURE integrity, posture, movement
The ability to move is fundamental to a high-quality life. The body's structural framework—comprising joints, bones, muscles, nerves, blood vessels, connective tissues, and fascia—acts like a coat hanger, holding each tissue in its designated place with just enough flexibility for function. This intricate system works synchronously, much like a well-tuned car, ensuring smooth and coordinated movement.
When mobility is compromised, stagnation sets in, leading to cellular and tissue deterioration, eventually contributing to organ dysfunction and decline. To prevent this, maintaining a strong and flexible body frame is essential. Our specialized Structure Restore peptide-based nutrient and supplementation formulas are designed to support structural integrity, promote mobility, and sustain overall musculoskeletal health.

PROCESS 8: STEM CELL REBORN
By the age of 60, the harsh reality is that the body's stem cell reserves stop replenishing, significantly slowing down the natural repair process. However, if the previous seven steps have been well-maintained, one can still enjoy good health into their 90s—and in some cases, even beyond 100. Yet, despite our best efforts, cells eventually perish. Stem cell therapy has emerged as a promising breakthrough, offering the potential to rejuvenate and extend vitality. By breathing new life into the body, it provides a second lease on life -a second bite of the apple - allowing individuals to pursue their goals, fulfill their purpose, and live with renewed energy.

Hello! We welcome any enquiry!
Leave me a message or contact info. Love to hear from you.
This website uses cookies.
We use cookies to analyze website traffic and optimize your website experience. By accepting our use of cookies, your data will be aggregated with all other user data.
